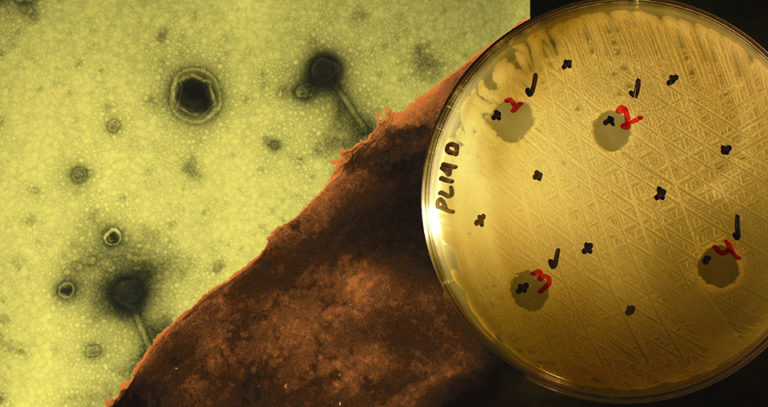

Responsibility
Phage therapy provides targeted bacteria treatment
The use of phages is an alternative to antibiotics in the control of pathogenic bacteria. Phage therapy offers low-cost, low-toxicity treatment and quick bactericidal effects.
Health & Welfare
Study demonstrates the feasibility of reducing the pathogenic Vibrio load in live feed and fish larvae with a non-antibiotic-based approach.
Responsibility
The use of phages is an alternative to antibiotics in the control of pathogenic bacteria. Phage therapy offers low-cost, low-toxicity treatment and quick bactericidal effects.